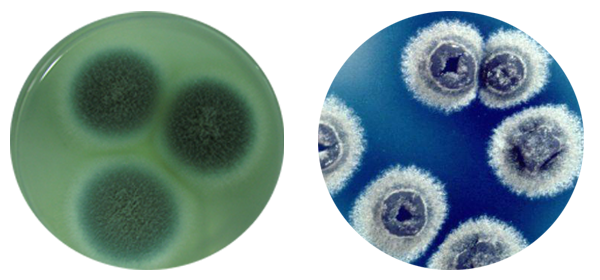

发酵罐,一个普通的容器,却孕育拯救生命的奇迹,这就是制药工业中不可或缺的反应器,它为微生物的生长和代谢提供了一个可控的环境。在现代制药工业中,发酵罐不仅是生物制造过程中的关键设备,更是推动生物技术发展的重要力量。
一、发酵罐用于抗生素的生产
抗生素是一类能够抑制或杀死微生物生长的药物,它们在治疗感染性疾病中发挥着重要作用。日常去医院,医生也会针对病人的不同问题给他们使用一些抗生素药物,可以说它在人们生活中并不陌生。
抗生素的生产通常依赖于微生物的发酵过程。发酵罐在其中究竟起怎样的作用呢?
抗生素的生产通常依赖于微生物的发酵过程。发酵罐在其中究竟起怎样的作用呢?

- 微生物培养:通过控制发酵罐内的环境条件,如温度、pH值、氧气供应等,为抗生素生产菌株提供无菌可控的最佳生长环境。
- 代谢产物积累:在适宜的条件下,微生物能够大量合成抗生素,这些抗生素随后通过对发酵液的分离和纯化过程被提取出来。例如,青霉素是由青霉菌产生的,而链霉素则由链霉菌产生。
- 过程优化:通过调整发酵参数,如培养基配方、改变补料策略等手段,可以优化抗生素的产量和质量。
-
抗生素的提取与纯化:发酵过程结束后,抗生素需要从发酵液中提取出来,并经过过滤、离心、萃取、浓缩等一系列的纯化步骤,以确保最终产品的安全性和有效性。
二、关于疫苗的发酵

疫苗是预防传染病的重要手段,它们通过刺激免疫系统产生对特定病原体的免疫反应来保护人体。许多疫苗的生产涉及到微生物的发酵,其制备过程同样依赖于发酵技术。
- 病原体培养:为了生产疫苗,科学家们可能需要筛选出毒力减弱但保留免疫原性良好的菌株,还可能会对微生物进行基因工程改造,使其能够表达病原体的特定抗原,这时就需要使用发酵罐来培养病毒或细菌。
- 灭活或减毒:在发酵过程中,病原体可能需要经过灭活或减毒处理,以确保疫苗的安全性。
- 规模化生产:发酵罐可以进行大规模的病原体培养,满足疫苗生产的需求。

三、发酵罐用于生物药物&酶的合成
生物药物和酶是现代制药工业中的另一重要领域。生物药物,如单克隆抗体和重组蛋白,这些药物在治疗各种疾病,如癌症和自身免疫疾病中发挥着重要作用。酶是生物体内的催化剂,它们在许多工业过程中也发挥着关键作用,包括制药工业。这些都可以通过微生物发酵技术进行大规模生产。
发酵罐在这一领域的应用同样广泛:
发酵罐在这一领域的应用同样广泛:
- 基因工程:通过基因工程技术,将目标基因导入微生物或细胞中,利用发酵罐进行大规模培养,生产所需的生物药物或酶。更多详情可参考往期文章了解
- 过程控制:精确控制发酵条件,如温度、pH、营养物质供应等,以优化生物药物或酶的表达和产量。
- 下游处理:发酵结束后,通过发酵罐的配套设备进行产物的提取、纯化和制剂,确保最终产品的质量和稳定性。
发酵罐在制药工业中的应用是多方面的,它不仅促进了抗生素、疫苗和生物药物的生产,还为酶的生物合成提供了必要的条件。随着生物技术的不断进步,发酵罐的设计和操作也在不断优化,以满足制药工业对效率和质量的日益增长的需求。
本站是Z6尊龙官方网站(HOLVES)品牌网站/,提供不同类型的行业资讯、技术知识、解决方案,我们研发和生产了多款新型实验室发酵罐、生物反应器、切向流超滤等设备,满足从实验到工业生产等各个需求环节,欢迎您垂询。









